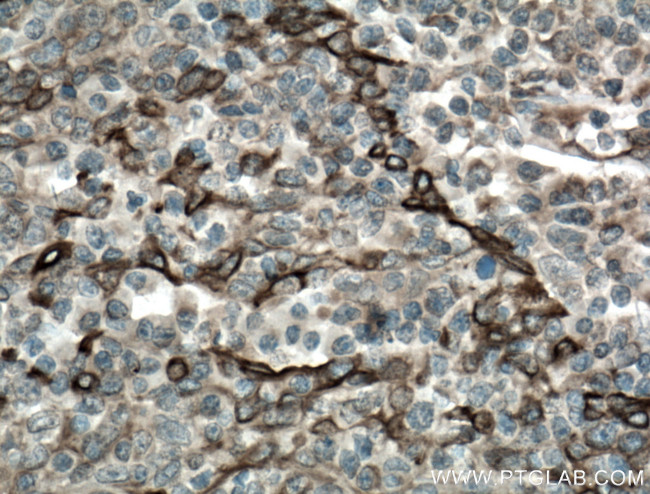
TLR8 Antibody in Immunohistochemistry (Paraffin) (IHC (P))

Search
Proteintech
TLR8 Monoclonal Antibody (3B6A4)
{{$productOrderCtrl.translations['antibody.pdp.commerceCard.promotion.promotions']}}
{{$productOrderCtrl.translations['antibody.pdp.commerceCard.promotion.viewpromo']}}
{{$productOrderCtrl.translations['antibody.pdp.commerceCard.promotion.promocode']}}: {{promo.promoCode}} {{promo.promoTitle}} {{promo.promoDescription}}. {{$productOrderCtrl.translations['antibody.pdp.commerceCard.promotion.learnmore']}}
产品信息
67317-1-IG
种属反应
宿主/亚型
分类
类型
克隆号
抗原
偶联物
形式
浓度
规格
纯化类型
保存液
内含物
保存条件
运输条件
产品详细信息
Aliquoting is unnecessary for -20°C storage.
靶标信息
The TLR8 protein is a member of the Toll-like receptor (TLR) family which plays a fundamental role in pathogen recognition and activation of innate immunity. TLRs are highly conserved from Drosophila to humans and share structural and functional similarities. They recognize pathogen-associated molecular patterns (PAMPs) that are expressed on infectious agents, and mediate the production of cytokines necessary for the development of effective immunity. The various TLRs exhibit different patterns of expression. The TLR8 gene is predominantly expressed in lung and peripheral blood leukocytes, and lies in close proximity to another family member, TLR7, on chromosome X.
仅用于科研。不用于诊断过程。未经明确授权不得转售。
篇参考文献 (0)
生物信息学
蛋白别名: CD antigen 288; CD288; TLR8; TLR8 isoform 1; Toll-like receptor 8; unnamed protein product
基因别名: CD288; hTLR8; IMD98; TLR-8; TLR8; UNQ249/PRO286
UniProt ID: (Human) Q9NR97
Entrez Gene ID: (Human) 51311